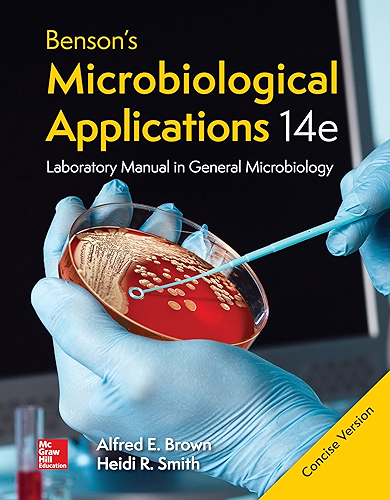

[Télécharger] Benson's Microbiological Applications, Laboratory Manual in General Microbiology, Concise Version (English Edition) de Alfred Brown PDF Ebook En Ligne
Télécharger Benson's Microbiological Applications, Laboratory Manual in General Microbiology, Concise Version (English Edition) de Alfred Brown Livre PDF Gratuit
Télécharger "Benson's Microbiological Applications, Laboratory Manual in General Microbiology, Concise Version (English Edition)" de Alfred Brown Francais PDF
Auteur : Alfred Brown
Catégorie : Boutique Kindle,Ebooks Kindle,Ebooks en langues étrangères
Broché : * pages
Éditeur : *
Langue : Français, Anglais
Benson's Microbiological Applications has been the "gold standard" of microbiology laboratory manuals for over 35 years. This manual has a number of attractive features that resulted in its adoption in universities colleges and community colleges. These features include user-friendly diagrams that students can easily follow clear instructions and an excellent array of reliable exercises suitable for beginning or advanced microbiology courses. In revising the lab manual for the fourteenth edition we have tried to maintain the proven strengths of the manual and further enhance it. We have updated the introductory material of the fungi protozoa and algae to reflect changes in scientific information. Finally the names of microorganisms used by the American Type Culture Collection. This is important for those users who rely on the ATCC for a source of cultures.
Télécharger Benson's Microbiological Applications, Laboratory Manual in General Microbiology, Concise Version (English Edition) de Alfred Brown Francais PDF
Benson's Microbiological Applications: Laboratory Manual ~ The classic resource for undergraduate microbiology laboratory courses just keeps getting better. The self-contained, clearly illustrated exercises and four-color format make Microbiological Applications: A Laboratory Manual in General Microbiology the ideal lab manual. Appropriate for either a majors or non-majors lab course, this lab manual assumes no prior organic chemistry course has been .
Benson's Microbiological Applications, Laboratory Manual ~ Benson's Microbiological Applications, Laboratory Manual in General Microbiology, Short Version, 13th Edition by Alfred Brown and Heidi Smith (9780073402413) Preview the textbook, purchase or get a FREE instructor-only desk copy.
Benson's Microbiological Applications Laboratory Manual ~ Benson's Microbiological Applications Laboratory Manual--Complete Version, 14th Edition by Alfred Brown and Heidi Smith (9781259919794) Preview the textbook, purchase or get a FREE instructor-only desk copy.
benson s microbiological applications laboratory manual in ~ BENSON'S MICROBIOLOGICAL APPLICATIONS: LABORATORY MANUAL IN GENERAL MICROBIOLOGY, COMPLETE VERSION (ebook. Read PDF Benson's Microbiological Applications: Laboratory Manual in General Microbiology, Complete Version (Authored by Brown,Alfred Released at 2006 Filesize: 2.51 MB Reviews This publication is definitely not effortless to get going on
Bensons Microbiological Applications Laboratory Manual In ~ Bensons Microbiological Applications Laboratory Manual In General Microbiology Complete Version . Laboratory Manual in General Microbiology Concise Version Kindle edition by Brown Alfred Download it once and read it on your Kindle device PC phones or tablets Use features like bookmarks note taking and highlighting while reading Benson s Microbiological Applications Laboratory Manual in .
Benson's Microbiological Applications: Laboratory Manual ~ Benson's Microbiological Applications: Laboratory Manual in General Microbiology, Short Version UG-51684 US/Data/Medical-Books 4.5/5 From 637 Reviews Alfred E Brown, Alfred Brown DOC / *audiobook / ebooks / Download PDF / ePub The classic resource for undergraduate microbiology laboratory courses just keeps getting better. The self-contained .
(PDF) Laboratory Manual in General Microbiology For ~ PDF / On Sep 8, 2012, Sulaiman M Alnaimat and others published Laboratory Manual in General Microbiology For Undergraduate Students., Short Version. / Find, read and cite all the research you need .
Benson's Microbiological Applications, Laboratory Manual ~ Benson's Microbiological Applications, Laboratory Manual in General Microbiology, Concise Version - Kindle edition by Brown, Alfred. Download it once and read it on your Kindle device, PC, phones or tablets. Use features like bookmarks, note taking and highlighting while reading Benson's Microbiological Applications, Laboratory Manual in General Microbiology, Concise Version.
Laboratory Manual and Workbook in Microbiology ~ Applications to Patient Care 7th Edition Josephine A. Morello Paul A. Granato Helen Eckel Mizer ISBN: 0-07-246354-6 Description: ©2003 / Spiral Bound/Comb / 304 pages Publication Date: June 2002 Overview This microbiology laboratory manual is designed especially for the non-majors, health science microbiology courses. The organization reflects the body systems approach and contains specific .
(PDF) Microbiology Laboratory Manual - ResearchGate ~ PDF / On Jan 1, 2014, Naveena Varghese and others published Microbiology Laboratory Manual / Find, read and cite all the research you need on ResearchGate
Benson's Microbiological Applications, Laboratory Manual ~ Unlike static PDF Benson's Microbiological Applications, Laboratory Manual in General Microbiology, Concise Version solution manuals or printed answer keys, our experts show you how to solve each problem step-by-step. No need to wait for office hours or assignments to be graded to find out where you took a wrong turn. You can check your reasoning as you tackle a problem using our interactive .
Benson’s Microbiological Applications, Laboratory Manual ~ Benson’s Microbiological Applications, Laboratory Manual in General Microbiology, Short Version. View/ Open. Benson-Microbiological-Applications.pdf (65.06Mb) Date 2014. Author. Brown, Alfred. Smith, Heidi. Metadata Show full item record. Abstract. Benson's Microbiological Applications has been the gold standard of microbiology lab manuals for over 30 years. The self-contained, clearly .
Bensons Microbiological Applications Laboratory Manual In ~ bensons microbiological applications short version laboratory manual in general microbiology Aug 27, 2020 Posted By Corín Tellado Publishing TEXT ID a927efec Online PDF Ebook Epub Library laboratory manual in general microbiology short version alfred brown heidi smith pdf 5488 399 8 items sold year2014 edition13 publishermcgraw hill education
Microbiological Applications Laboratory Manual in General ~ Microbiological Applications Laboratory Manual in General Microbiology (Complete Version, Eighth Edition) [Harold J. Benson] on Amazon. *FREE* shipping on qualifying offers. Microbiological Applications Laboratory Manual in General Microbiology (Complete Version, Eighth Edition)
Microbiological Applications: A Laboratory Manual in ~ Just like its 'complete version' sibling, the price of this 'short version' "Microbiological Applications" lab manual is on the high side. However, the book did a good job in sieving and replicating, (as concise as possible), the contents of its 'big-brother'. This manual dealt with every practical issue relating to undergraduate microbiology .
Benson's Microbiological Applications Complete Version 13 ~ Benson's Microbiological Applications Complete Version - Kindle edition by Brown. Download it once and read it on your Kindle device, PC, phones or tablets. Use features like bookmarks, note taking and highlighting while reading Benson's Microbiological Applications Complete Version.
Benson's Microbiological Applications, Laboratory Manual ~ benson's microbiological applications has been the gold standard of microbiology lab manuals for over 30 years. The self-contained, clearly-illustrated exercises and four-color format makes this the ideal lab manual. Appropriate for either a majors or non-majors lab course, this manual assumes no prior organic chemistry has been taken.
Bensons Microbiological Applications Laboratory Manual In ~ Bensons Microbiological Applications Laboratory Manual In General Microbiology Complete Version 13th Edition Paperback [PDF] Bensons Microbiological Applications Laboratory Manual In General Microbiology Complete Version 13th Edition Paperback Yeah, reviewing a book Bensons Microbiological Applications Laboratory Manual In General Microbiology Complete Version 13th Edition Paperback could .
Benson S Microbiological Applications Laboratory Manual In ~ Benson S Microbiological Applications Laboratory Manual In General Microbiology is available in our book collection an online access to it is set as public so you can get it instantly. Our book servers hosts in multiple locations, allowing you to get the most less latency time to download any of our books like this one.
Bensons's Microbiological Application: Laboratory Manual ~ Buy Bensons's Microbiological Application: Laboratory Manual, Short 11th edition (9780073522548) by Alfred E. Brown for up to 90% off at Textbooks.
0072823976 - Benson's Microbiological Applications ~ Bensons Microbiological Applications: Laboratory Manual in General Microbiology, Short Version by Brown, Alfred E and a great selection of related books, art and collectibles available now at AbeBooks.
Benson's Microbiological Applications: Laboratory Manual ~ The classic resource for undergraduate microbiology laboratory courses just keeps getting better. The self-contained, clearly illustrated exercises and full-color format make Microbiological Applications: Laboratory Manual in General Microbiology the ideal lab manual. Appropriate for either a majors or non-majors lab course, this manual assumes no prior organic chemistry course has been taken.
LooseLeaf Benson's Microbiological Applications Laboratory ~ Benson's Microbiological Applications has been the "gold standard" of microbiology laboratory manuals for over 35 years. This manual has a number of attractive features that resulted in its adoption in universities, colleges, and community colleges. These features include user-friendly diagrams that students can easily follow, clear instructions, and an excellent array of reliable exercises .
Benson’s Microbiological Applications, Laboratory Manual ~ Benson’s Microbiological Applications, Laboratory Manual in General Microbiology, 14th Edition. Benson’s Microbiological Applications has been the “gold standard” of microbiology laboratory manuals for over 35 years. This manual has a number of attractive features that resulted in its adoption in universities colleges and community colleges. These features include user-friendly .
Comments
Post a Comment